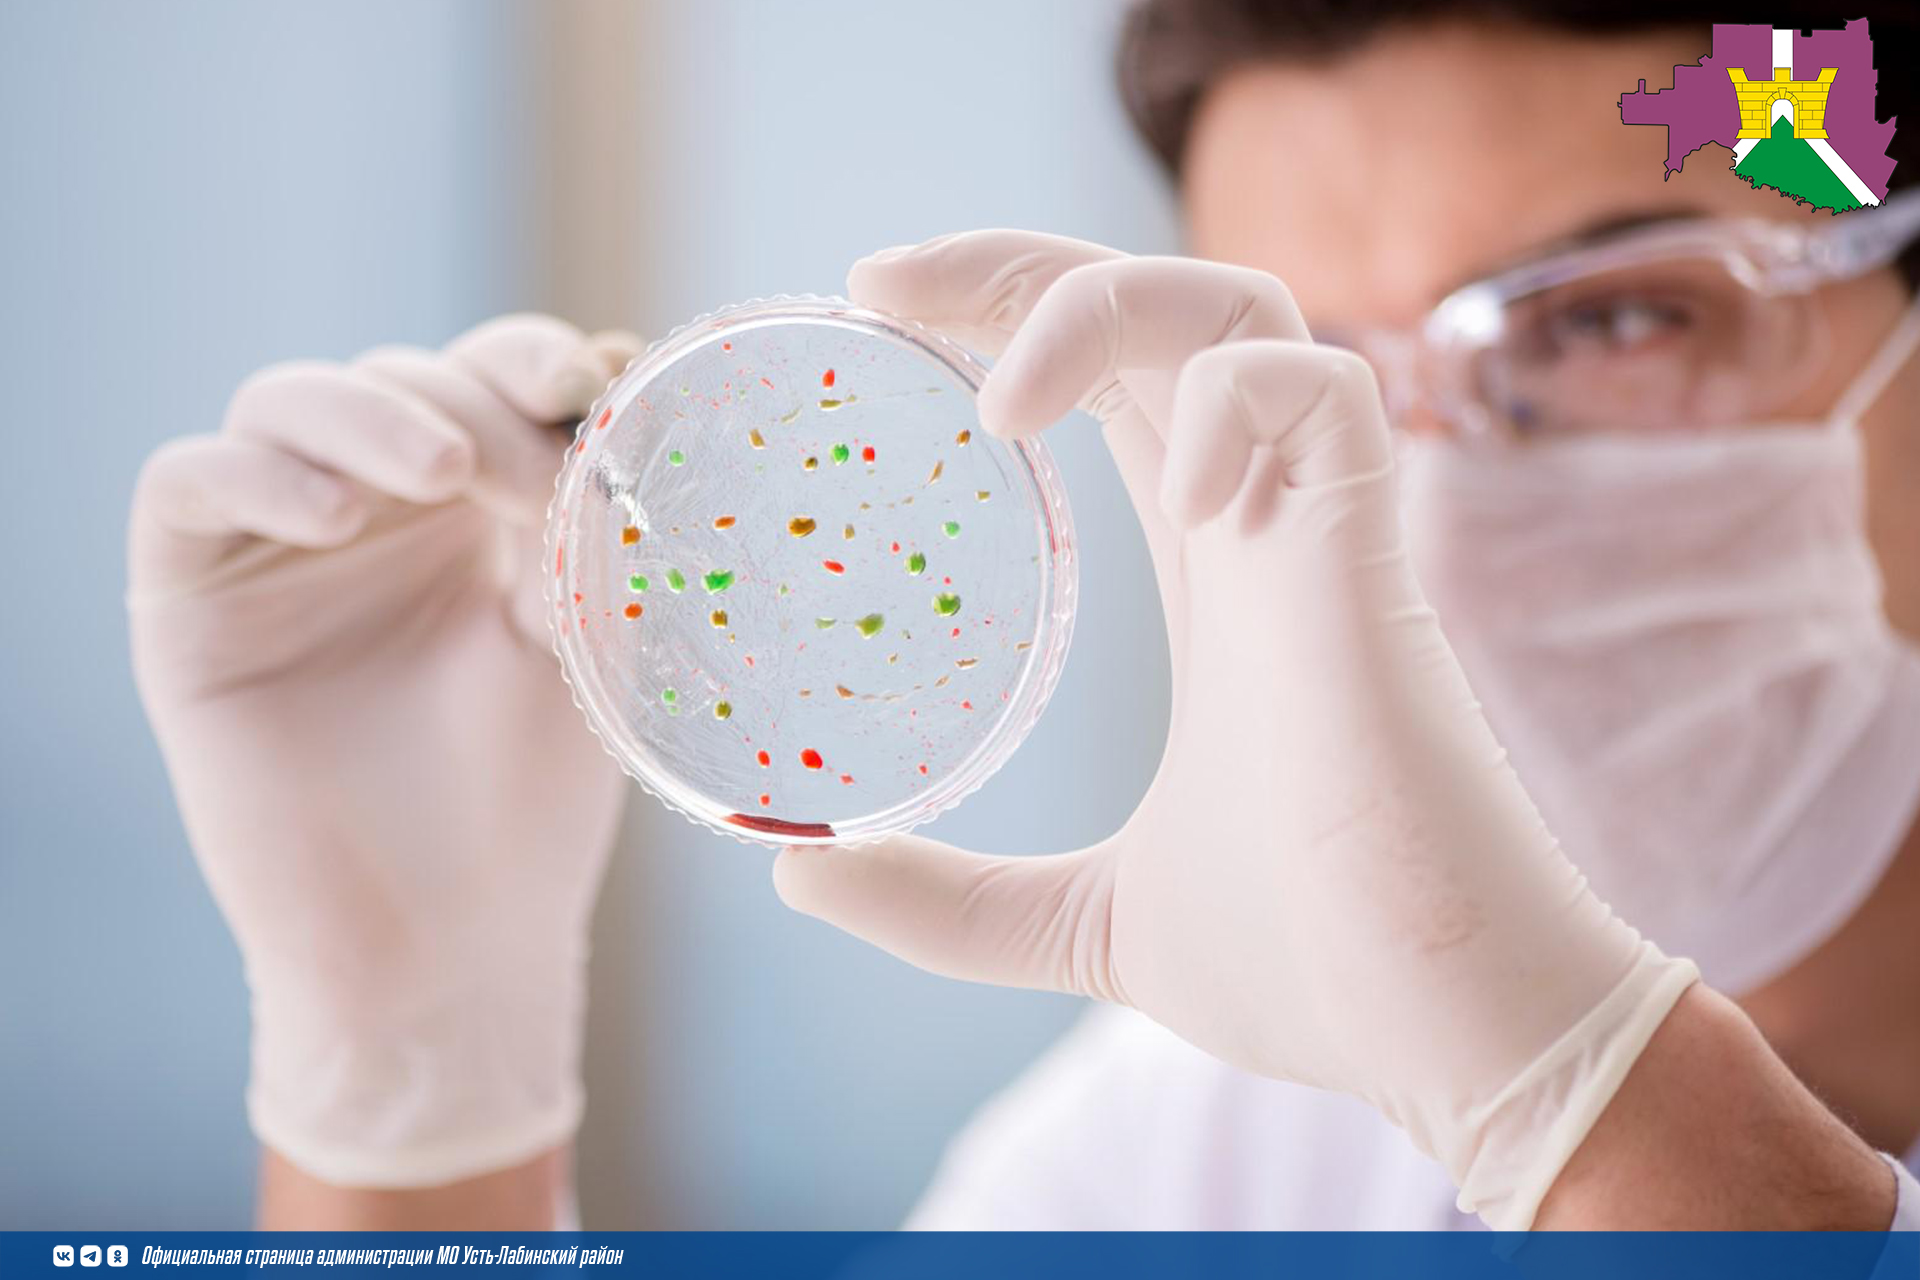

Профилактика острых кишечных инфекций
Острые кишечные инфекции (ОКИ) это большая группа инфекционных заболеваний человека с энтеральным (фекально-оральным) механизмом заражения, вызываемых бактериями, вирусами и простейшими, протекающие с преимущественным поражением желудочно-кишечного тракта в тяжелых случаях - с явлениями токсикоза и эксикоза.
Причиной возникновения ОКИ: бактерии - сальмонелла, шигелла (возбудитель дизентерии), энтеропатогенные кишечные палочки, стафилококки, иерсинии и др.; вирусы - ротавирус, норовирус, а также - энтеровирусы, астровирусы, аденовирусы; грибы, простейшие. Для возбудителей бактериальных кишечных инфекций характерна летняя сезонность, для вирусных кишечных инфекций осенняя и зимняя.
В передаче возбудителей могут участвовать несколько основных факторов: вода, пищевые продукты, почва, предметы обихода, насекомые и т.д. В пищевых продуктах возбудители кишечных инфекций не только сохраняются, но и активно размножаются, не меняя при этом внешнего вида и вкус продукта.
Основными проявлениями острой кишечной инфекции являются слабость, плохой аппетит, диарея, рвота, боли в животе, повышение температуры тела, озноб. К наиболее опасным осложнениям кишечных инфекций следует отнести хирургические: перитонит, кишечная непроходимость, кровотечение, парез кишечника и другие.
Профилактика ОКИ включает общегигиенические и медицинские мероприятия, проводимые постоянно, вне зависимости от времени года и от уровня заболеваемости - выявление источника инфекции, изоляция его и начало лечения. В помещении, где находился больной, проводится дезинфекция.
Основные меры личной профилактики:
-Тщательно соблюдать гигиену рук.
-Вакцинироваться от кишечных инфекций.
-Пить безопасную воду – кипяченую или бутилированную.
-Тщательно мыть овощи, фрукты, зелень и ягоды.
-Правильно проводить термическую обработку продуктов (мяса, яиц, рыбы и др.), а также соблюдать сроки и правила хранения пищи.
-Покупать продукты только в установленных местах торговли.
-Соблюдать чистоту на собственной кухне. Обращать внимание на порядок и чистоту в точках общественного питания.
-Купаться только в разрешенных водоемах. При купании в бассейнах и водоемах не допускать попадания в рот и заглатывания воды.
ЧТО делать в случае заболевания
Срочно обратиться за медицинской помощью, чтобы получить грамотное лечение и избежать опасных осложнений.Изолировать больного, выделить ему отдельное полотенце и посуду. При уходе за инфицированным соблюдать гигиену: часто мыть руки с мылом, регулярно проводить дома влажную уборку и проветривание, а при необходимости дезинфекцию. Это позволит снизить риск передачи инфекции здоровым членам семьи.
27 апреля 2026 05:16